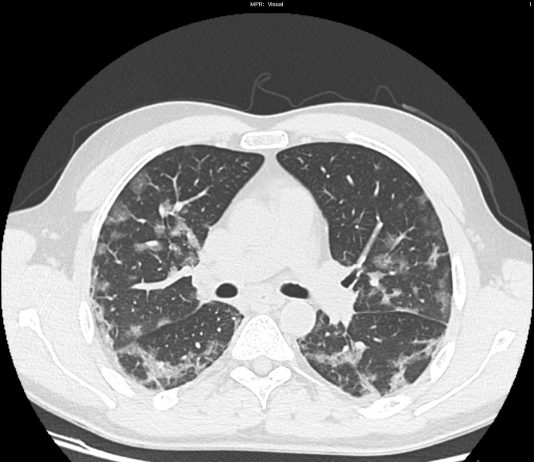
COVID-19: case 4

UOC Radiologia ASST Bergamo Est Direttore Dr Gianluigi Patelli
50-year-old male outpatient presented for a chest radiography. He reported with sick cough asthenia and fever for two days, with progressive worsening of his clinical conditions. pO2: 93%.
Chest radiography
UOC Radiologia ASST Bergamo Est Direttore Dr Gianluigi Patelli
61-year-old female
patient with fever (37.8°C) cough and asthenia. pO2: 98%. Previous flu symptoms
in November 2019, treated with antibiotics.
After the chest film, the patient underwent CT for a better characterization of...
Anna Simeone
Casa Sollievo della Sofferenza - San Giovanni Rotondo
58-year-old male
patient presented to the ED for syncope after physical effort. Upper
respiratory inflammation with cough for few days. No previous medical history.
No recent travel.
T: 37.5°C; CBC normal.
UOC Radiologia - AO Sant’Orsola - Bologna
A55-year-old patient with persistent fever, recently underwent prostatectomy, performing uro-CT scan in the suspicious of abdominal collection.
In the lower portion of the lungs included in the...
UOC di Radiologia Diagnostica e Interventistica, Ospedale Madonna delle Grazie, ASL 4 - Matera
60-year-old male patient with fever for three days, coming from the “high-risk” zone. RT-PCR test positive
HRCT
A cura di G.Patelli, A. Lenzi, F.Besana,S. Paganoni,, F. Codazzi, G.Colao, C.Coluccia, E.Faietti, G.Ghilardi
UOC Radiologia ASST Bergamo Est - Direttore Dr. Gianluigi Patelli
73-year-old female
patient with fever and respiratory distress.
The patient was intubated in the...
Radiologia ASST Cremona
43-year-old male patient
with fever, cough. No previous medical history. Exposure to Covid-19 patients.
Respiratory failure (hypoxemia and hypercapnia). Leukopenia. Nasal swab positive for SARS-CoV-2.
HRCT
Figura 1
Radiologia ASST Cremona
32-year-old female
patient in treatment with steroids for autoimmune disease. No exposure to
Covid-19 patients (first Covid + patient in Cremona).
Fever and cough, leukocytosis. Respiratory failure (hypoxemia and hypocapnia).
HRCT
Figura...
Radiologia ASST Cremona
63-year-old male patient with no previous medical history. Exposure to Covid-19 patients. Fever, cough.
Respiratory failure (hypoxemia and hypocapnia). Leukocitosis. Nasal swab positive for SARS-CoV-2.
HRCT
Figura 1
Radiologia ASST Cremona
45-year-old male
patient with fever, cough. No previous medical history. Potential exposure to
Covid-19 patients.
Respiratory failure (hypoxemia and hypocapnia). Leukopenia. Nasal swab positive for SARS-CoV-2.
HRCT